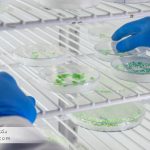
برآورد عدم قطعیت در کشت میکروبی و شمارش کلونیها

ردیابی اندازهگیری و کالیبراسیون تجهیزات یکی از ارکان حیاتی در تضمین صحت و دقت دادههای آزمایشگاهی است که مستقیماً بر کیفیت تولید و ایمنی محصولات دارویی، غذایی و دامپزشکی تأثیرگذار است. استاندارد بینالمللی ISO/IEC 17025 به عنوان چارچوبی جامع، الزامات فنی و مدیریتی را برای آزمایشگاهها و مراکز کالیبراسیون تدوین کرده است تا اعتبار نتایج اندازهگیری تضمین شود. در این مقاله، به بررسی مفاهیم کلیدی ردیابی و کالیبراسیون تجهیزات، الزامات مرتبط با استاندارد 17025 و راهکارهای عملی پیادهسازی آن در صنایع حساس میپردازیم.

استاندارد ISO/IEC 17025 به عنوان یکی از پرکاربردترین استانداردها در آزمایشگاههای آزمون و کالیبراسیون شناخته میشود. این استاندارد تضمین میکند که تجهیزات اندازهگیری و روشهای آزمون به صورت نظاممند مدیریت، کالیبره و ردیابی شده، تا نتایج قابل اطمینان و تکرارپذیر در اختیار مصرفکنندگان قرار گیرد. بهویژه در صنایع دارویی، غذایی و دامپزشکی که خطاهای اندازهگیری میتواند عواقب جبرانناپذیری بر سلامت و ایمنی داشته باشد، رعایت این استاندارد ضروری است.
ردیابی اندازهگیری به معنای توانایی مرتبط ساختن نتایج اندازهگیری با استانداردهای مرجع ملی یا بینالمللی از طریق زنجیرهای مستمر از مقایسهها است. این قابلیت، اطمینان میدهد که مقادیر اندازهگیری شده در آزمایشگاهها قابل ارجاع به معیارهای جهانی و قابل اعتماد باشد. به عبارت دیگر، ردیابی تضمین میکند که دادههای آزمایشگاهی به استانداردهای بینالمللی نظیر NIST، PTB یا IRMM وابسته و قابل تطبیق باشند.
ردیابی اندازهگیری نهتنها تضمینی است برای دقت تجهیزات، بلکه پایهای است برای اجرای موفق سیستمهای مدیریت کیفیت مانند GMP، GLP و HACCP. بدون ردیابی معتبر، هیچ آزمایشگاه یا خط تولید نمیتواند ادعای دقت و صحت دادههای خود را داشته باشد. به خصوص در فرایندهای پیچیده آزمایشگاهی مانند qPCR برای تایید میکروبیولوژیک محصولات یا HPLC/LC-MS جهت شناسایی ناخالصیها، ردیابی اندازهگیری اهمیت دوچندان مییابد.
کالیبراسیون عبارت است از تنظیم، مقایسه و تعیین خطاهای دستگاههای اندازهگیری نسبت به استانداردهای مرجع. هدف نهایی کالیبراسیون تضمین صحت اندازهگیری، کاهش خطا و تضمین انطباق با الزامات فنی استاندارد ISO/IEC 17025 است. کالیبراسیون به دو دسته کلی تقسیم میشود:
یکی از اصول اساسی ISO/IEC 17025، مستندسازی دقیق کلیه فرآیندهای کالیبراسیون است. تمام دادهها، نتایج اندازهگیری، و بازخوردهای فنی باید ثبت شده و در دسترس تیمهای کنترل کیفیت قرار گیرد. این مستندات ابزار مهمی برای ممیزیهای داخلی و خارجی، پیگیری کیفیت و اثبات انطباق با مقررات ISIRI، استانداردهای HACCP و GMP محسوب میشود.

در استاندارد ISO/IEC 17025، تجهیزات اندازهگیری باید از نظر صحت، قابلیت اطمینان و تناسب با کاربرد مورد تایید قرار گیرند. علاوه بر آن، تجهیزات باید به طور مستمر تحت فرآیندهای کالیبراسیون و بازنگری قرار گیرند. سیستمهای مدیریت کیفیت در آزمایشگاهها اغلب ابزارهایی نظیر آزمونهای DQ/IQ/OQ/PQ، شمارش ذرات در کلینروم، یا تستهای HEPA leak را به کار میگیرند تا شرایط محیطی و پارامترهای فنی کاملاً تحت کنترل باشند.
فرآیند ردیابی اندازهگیری در آزمایشگاههای دارویی و غذایی شامل مراحل زیر است:
این فرآیند همواره باید تحت نظارت دقیق مدیران کیفیت و بازرسین اعتباربخشی باشد.
مدیران کنترل کیفیت و تضمین کیفیت نقش کلیدی در پیادهسازی و حفظ چرخه کالیبراسیون ایفا میکنند. وظایف آنها عبارتند از:
انتخاب تجهیزات اندازهگیری باید با توجه به دقت مورد نیاز، نوع آزمون یا خط تولید و شرایط کاری صورت گیرد. برای مثال، در خطوط تولید دارویی که از سیستمهای HPLC و qPCR برای آنالیز ناخالصی و تایید هویت نمونه استفاده میشود، تجهیزاتی با دقت بالا و قابلیت نگهداشت کالیبراسیون ضروری است.
زمانبندی کالیبراسیون بر اساس توصیههای سازنده و تجربیات داخلی تنظیم میشود. در آزمایشگاههای تخصصی، ممکن است کالیبراسیون ماهانه یا حتی هفتگی برای دستگاههای حساس و پرکاربرد اعمال گردد.
ابزارهای نمونهبرداری نقش مهمی در اعتبارسنجی نتایج کالیبراسیون ایفا میکنند. با استفاده از پروتکلهای استاندارد مثل SOP و رعایت اصول فرآیندهای CIP و نمونهبرداری صحیح محیط کلینروم، میتوان اطمینان حاصل کرد که دادههای کالیبراسیون نماینده واقعی شرایط کاری و فنی دستگاهها هستند.
تحلیل دادهها با روشهای آماری و نرمافزارهای تخصصی، شامل شناسایی گرایشها، تغییرات و تخلفات، گام مؤثری در تصمیمگیری به موقع درباره تعمیرات، تنظیم مجدد یا تعویض تجهیزات است. این روشها در اعتبارسنجی سیستمهایی مانند ICP-OES و شمارش کلونی میکروبی نیز کاربرد فراوان دارند.

ردیابی اندازهگیری به قابلیت ردیابی نتایج اندازهگیری به استانداردهای مرجع بینالمللی اشاره دارد که از طریق زنجیرهای مستمر از مقایسات و کالیبراسیونها تضمین میشود.
کالیبراسیون دقت و صحت اندازهگیریها را تضمین کرده و کیفیت نتایج آزمایشگاهی را حفظ میکند، به طوری که اطمینان حاصل شود دستگاهها مطابق با استانداردهای فنی عمل میکنند.
این استاندارد، الزامات فنی و مدیریتی را برای صحت و قابلیت اطمینان نتایج آزمایش تعیین میکند و بر ضرورت کالیبراسیون تجهیزات و مستندسازی دقیق آنها تأکید دارد.
با استفاده از سازمانهای مرجع معتبر دارای اعتبار جهانی و ثبت دقیق مدارک کالیبراسیون در سیستمهای مدیریت کیفیت آزمایشگاهها میتوان به اعتبار کالیبراسیون اطمینان یافت.
مدیران QC/QA مسئول اطمینان از اجرای صحیح فرآیندهای کالیبراسیون، آموزش کارکنان و نظارت مستمر بر ثبتها و تجهیزات هستند تا از انطباق کامل با استانداردها مطمئن شوند.